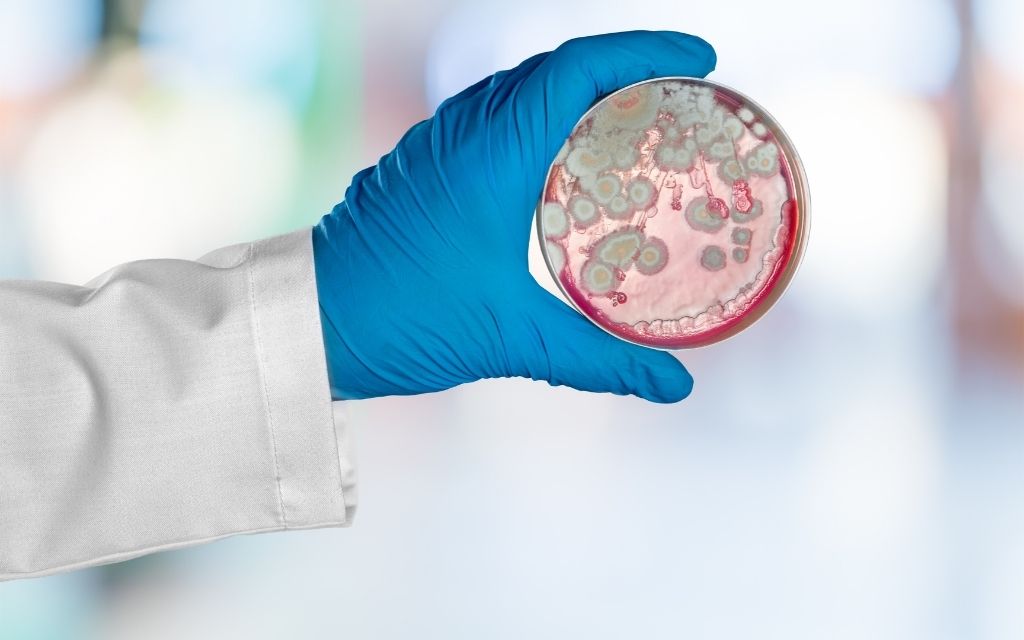

NEWS:
- Start
- Porady pszczelarskie
- Działy Pasieki »
NAUKA W PASIECE
Sekcja „Nauka w pasiece” na Pasieka24.pl oferuje artykuły edukacyjne o nowościach, badaniach i praktykach pszczelarskich, w tym o chorobach pszczół, ochronie zdrowia uli oraz optymalizacji pasiek, skierowane do pszczelarzy z pasją.
-
Ziobrowska-Sztuczka JustynaAnaliza ekonomicznej wartości zapylania i pszczelarstwa dla PKB Polski i UE, wpływu na plony, handel i rynek pracy oraz roli pszczół w zrównoważonym rozwoju, bezpieczeństwie żywnościowym i adaptacji do zmian klimatu.
-
Wydawnictwo PasiekaCzy technologia 5G wpływa na pszczoły? Co mówią badania na ten temat? Wokół sieci 5g narosło wiele mitów, a te w kontekście pszczół rozwiewamy w tym artykule.
-
Wydawnictwo PasiekaJak donosi pismo „Insect Science”, samotnice z gatunku Osmia excavata (murarka) pełnią funkcję żywych detektorów, których mikrobiom jelitowy precyzyjnie rejestruje kondycję ekologiczną metropolii.
-
Wydawnictwo PasiekaBadacze udowodnili, że trzmiele potrafią nie tylko precyzyjnie oceniać upływ czasu, ale również uczyć się interpretacji abstrakcyjnych sygnałów świetlnych przypominających uproszczoną wersję alfabetu Morse’a.
-
Wydawnictwo Pasieka. Badając skamieniałości z okresu czwartorzędu, natrafiono na unikalne ślady nazwane Osnidum almontei. Są to doskonale zachowane komórki lęgowe, które samotne pszczoły umiejscowiły w niezwykle specyficznych lokalizacjach, takich jak zębodoły wymarłych gryzoni, kanały kręgowe i jamy szpikowe.
-
Wydawnictwo PasiekaProjekt, który oficjalnie wystartował w październiku 2025 roku, ma na celu wypełnienie luki w naszej wiedzy na temat relacji między jakością gleby a dobrostanem owadów.
-
AdministratorCzy miód skrystalizowany jest zepsuty? Czy jak miód stwardnieje, to znaczy, że się zepsuł? Czy miód scukrzony jest dobry?
-
Kania ArturOdkryj tajemnice szczecinek kłujących aparatu żądłowego pszczół miodnych: ich budowę, zadziorki, role w wstrzykiwaniu jadu oraz różnorodność typów u robotnic i matek. Analiza ewolucji, skutków dla pszczół i inspiracje dla inżynierii medycznej. Fascynujące spojrzenie na broń pszczół!
-
Nicewicz AgataArtykuł prezentuje wyniki badań porównujących właściwości prozdrowotne miodów z Polski, Europy i świata. Opis aktywności enzymatycznej, zawartości polifenoli, działania antyoksydacyjnego, przeciwbakteryjnego oraz problemu mikroplastiku w miodzie.
-
Wydawnictwo Pasieka„Tropilaelaps. U bram twojej pasieki” to kompendium wiedzy o groźnym pasożycie pszczół. Autorzy łączą praktykę i naukę, pokazując realne zagrożenia oraz skuteczne metody wykrywania i zwalczania. Lektura obowiązkowa dla każdego pszczelarza!
-
Martyna WalerowiczArtykuł pokazuje złożone relacje między ptakami a pszczołami: od drapieżnictwa po korzyści dla upraw i ochrony roślin miododajnych. Wyjaśnia, jak ptaki ograniczają szkodniki, jak mogą pomagać w walce z szerszeniami oraz jakie są skutki ingerencji człowieka.
-
Kobiałka TeresaDzięki szybkiemu postępowi technologicznemu pszczelarstwo wkracza w erę precyzyjnego monitorowania, w tym także dokładnej obserwacji lotów godowych matek. Jak zauważa dr Jay Evans z USDA Beltsville Bee Lab, wiedza na temat aktywności w tzw. obszarach zgromadzeń trutni wymagała odświeżenia.
-
AdministratorAnalizie poddano próbki miodów z 35 pasiek. Naukowcy skupili się na ich właściwościach biochemicznych, antyoksydacyjnych i przeciwdrobnoustrojowych. Analizowano również zanieczyszczenie miodu mikroplastikiem.
-
AdministratorOpis ekologicznych uli pszczelich wykonanych z wapna, padzierzy konopnych i wełny owczej oraz ich właściwości i zastosowania.
-
AdministratorPrzegląd właściwości miodu i produktów pszczelich w kosmetyce, ich historia, działanie na skórę i włosy oraz praktyczne zastosowania.
-
Waś EwaAnaliza różnic między miodem płynnym (patoka) a skrystalizowanym (krupiec), ich wartości odżywcze i preferencje konsumentów.
-
Kapler AdamAnaliza błędów i uproszczeń w kampaniach społecznych dotyczących ochrony pszczół i zapylaczy. Omówienie zjawiska beewashing, czyli fałszywych działań na rzecz pszczół, oraz konieczności właściwej edukacji i precyzyjnej terminologii.
-
Kapler Adam
-
Gajda Anna
-
Jaroński Jakub
-
Martyna Walerowicz
-
Gajda Anna
-
Jaroński Jakub
-
Martyna Walerowicz
-
Gajda Anna
-
Gajda Anna
-
Martyna Walerowicz
-
Rafał Szyrszeń
-
Martyna Walerowicz
-
Jaroński Jakub
-
Kapler Adam
-
Teper Dariusz
-
Martyna Walerowicz
-
Nicewicz Agata
-
Kapler Adam
-
Nicewicz Agata
-
Gajda Anna
-
Kobiałka TeresaCzy zastanawialiście się kiedyś, dlaczego niektóre pszczoły wydają się bardziej aktywne, „rozmowne” i zintegrowane, podczas gdy inne trzymają się z boku? Okazuje się, że kluczem do tej zagadki mogą być... geny.
-
Kobiałka TeresaNajnowsze badania naukowe sugerują, że pszczoły posiadają zdolności matematyczne, które wykraczają daleko poza nasze dotychczasowe wyobrażenia. Okazuje się, że pszczoły miodne potrafią nie tylko liczyć, ale także rozróżniać liczby parzyste od nieparzystych!
-
Kobiałka TeresaPszczoły miodne są o wiele bardziej efektywne w zapylaniu borówki, niż wcześniej sądzono.
-
Ziobrowska-Sztuczka Justyna
-
Administrator
-
Szymański Emil Mariusz
-
-
Jaroński Jakub
-
Kapler Adam
-
AdministratorAnaliza fazy foretycznej Varroa destructor wskazuje, że nie uległa ona skróceniu, a dotychczasowe modele dynamiki rozwoju pasożyta pozostają aktualne. Badanie uwzględniało współczynniki rozmnażania i wpływ fazy foretycznej na leczenie.
-
Wydawnictwo Pasieka
-
Kobiałka TeresaZespół prof. Franceski Barbero z Uniwersytetu w Turynie dowiódł, że popularne w ogrodach lwie paszcze (wyżliny) reagują na dźwięki zapylaczy. Gdy tylko do ich kwiatów dociera charakterystyczne bzyczenie makatki czerwonej (Rhodanthidium sticticum) – rośliny zwiększają stężenie cukru w nektarze oraz z
-
Burzyńska Marta
-
Kobiałka TeresaGdzie matka pszczela załatwia swoje potrzeby fizjologiczne, skoro nie wylatuje z ula?
-
Kołtowski Zbigniew
-
Burzyńska Marta
-
Wydawnictwo Pasieka
-
Administrator
-
Kapler Adam
-
Wydawnictwo Pasieka
-
Kobiałka TeresaOdrestaurowane łąki cechują się znacząco niższym bogactwem roślin, mniej wyspecjalizowanymi (bardziej uogólnionymi) sieciami interakcji, niższym sukcesem zapylania i ograniczonym dostępem pyłku nasion rodzimych roślin w porównaniu ze starymi łąkami. Ich odbudowa zajmuje ponad 75 lat.
-
-
Burzyńska Marta
-
Mazur EwaZ artykułu dowiesz się m.in.: ile proc. wynosiły straty rodzin pszczelich po zimowli 2023/2024; w której kategorii straty były najdotkliwsze; w których województwach straty były największe, a w których najmniejsze.
-
Administrator
-
Kapler Adam
-
Kobiałka TeresaEdukacja na rzecz ochrony klimatu, dzikich zapylaczy oraz rodzimych gatunków roślin
-
Burzyńska Marta
-
AdministratorZ artykułu dowiesz się m.in.: w jaki sposób pszczoły, trzmiele i motyle wpływają na plony upraw, produkcję miodu oraz różnorodność biologiczną; czy miedze i pobocza dróg są kluczowe dla przetrwania tych pożytecznych owadów; jakie gatunki roślin są najbardziej atrakcyjne dla pszczół, trzmieli i motyli.
-
Ziobrowska-Sztuczka Justyna
-
Jaroński Jakub
-
Kapler Adam
-
-
Kobiałka Teresa
-
Waś Ewa
-
Gajda Anna
-
Rafał Szyrszeń
-
-
Kiljanek Tomasz
-
Gajda Anna
-
-
-
Burzyńska Marta
-
-
-
-
-
-
-
-
-
-
Burzyńska Marta
-
-
-
-
-
-
-
-
Gajda Anna
-
Martyna Walerowicz
-
Martyna Walerowicz
-
Martyna Walerowicz
-
Martyna Walerowicz
-
Aneta Strachecka
-
Aneta Strachecka
-
Aneta Strachecka
-
Aneta Strachecka
-
Aneta Strachecka
-
Aneta Strachecka
-
Aneta Strachecka
-
Aneta Strachecka
-
Aneta Strachecka
-
Aneta Strachecka
-
Aneta Strachecka
-
Aneta Strachecka
-
Aneta Strachecka
-
Aneta StracheckaOmówienie gruczołów głowy pszczoły miodnej: ślinowych, gardzielowych i żuwaczkowych. Budowa komórkowa, wydzielane substancje, feromony, rola w komunikacji, karmieniu larw, przerabianiu nektaru na miód oraz determinacji kasty i zachowaniu robotnic
-
Aneta Strachecka
-
Aneta StracheckaŻądło pszczoły miodnej to złożony narząd obronny złożony z 10 części, połączony z gruczołami jadowym, alkalicznym i Kożewnikowa. Wydzieliny żądła pełnią funkcje obronne i komunikacyjne, a żądlenie skutkuje obroną gniazda kosztem życia pszczoły
-
Aneta Strachecka
-
Aneta Strachecka
-
Aneta Strachecka
-
Martyna Walerowicz
-
-
Mazur Ewa
-
Administrator
-
-
Kobiałka Teresa
-
Martyna Walerowicz
-
Burzyńska Marta
-
Jaroński Jakub
-
Martyna Walerowicz
-
-
Martyna Walerowicz
-
Martyna Walerowicz
-
-
-
-
Woźna-Burdziak Weronika
-
Gajda Anna
-
Martyna Walerowicz
-
-
Martyna Walerowicz
-
Martyna Walerowicz
-
Martyna Walerowicz
-
Martyna Walerowicz
-
Martyna Walerowicz
-
-
-
-
-
-
Burzyńska Marta
-
Martyna Walerowicz
-
-
-
-
Martyna Walerowicz
-
-
-
-
-
Janicka Maria
-
Mazur Ewa
-
-
-
-
-
-
Martyna Walerowicz
-
Piątek Michał
-
Jaroński Jakub
-
Martyna Walerowicz
-
Martyna Walerowicz
-
Martyna Walerowicz
-
Burzyńska Marta
-
Rafał Szyrszeń
-
Szymański Emil Mariusz
-
-
-
Nicewicz Agata
-
Waś Ewa
-
Wydawnictwo Pasieka
-
-
-
-
Martyna Walerowicz
-
-
-
Martyna Walerowicz
-
Paleolog Jerzy
-
Mazur Ewa
-
Deprecated: htmlspecialchars(): Passing null to parameter #1 ($string) of type string is deprecated in /home/pasieka/domains/pasieka24.pl/public_html_dev3/templates/wt_news/html/com_tags/tag/default_items.php on line 132
-
Martyna Walerowicz
-
Martyna Walerowicz
-
Martyna Walerowicz
-
-
Martyna Walerowicz
-
-
-
Martyna Walerowicz
-
Martyna Walerowicz
-
Waś Ewa
-
Paleolog Jerzy
-
Burzyńska Marta
-
Janicka Maria
-
Kobiałka Teresa
-
-
Martyna Walerowicz
-
-
Martyna Walerowicz
-
Martyna Walerowicz
-
Martyna Walerowicz
-
-
-
Waś Ewa
-
Martyna Walerowicz
-
Paleolog Jerzy
-
Burzyńska Marta
-
Janicka Maria
-
Jaroński Jakub
-
Martyna Walerowicz
-
Martyna Walerowicz
-
-
Martyna Walerowicz
-
-
-
Martyna Walerowicz
-
Paleolog Jerzy
-
Burzyńska Marta
-
Waś Ewa
-
Gajda Anna
-
-
Martyna Walerowicz
-
-
Nowak AdrianaJakie są objawy zatruć pszczół i jak pestycydy wpływają m.in. na układ pokarmowy zbieraczek. Od czego zależy zdolność bakterii fermentacji mlekowej do detoksykacji pestycydów. Czy wszystkie probiotyki wykazują właściwości detoksykacyjne
-
Paleolog JerzyOd czego zależy dynamika wzrostu populacji roztoczy Varroa destructor Dlaczego zdolność odsklepiania i ponownego zasklepiania czerwiu przez pszczoły jest tak ważna W jakim stopniu oczyszczanie się pszczół miodnych z dręcza jest cechą uwarunkowaną genetycznie
-
Gajda AnnaSkąd się wzięła wątpliwość odnośnie do zwalczania zgnilca amerykańskiego pszczół. Czy w najbliższej przyszłości nadal będzie można uzyskać odszkodowanie w przypadku wystąpienia choroby. Dlaczego warto zgłaszać podejrzenie zgnilca do powiatowego lekarza weterynarii.
-
Gajda AnnaJak długo antybiotyki pozostają w wosku pszczelim. Czy autoklawowaniem można usunąć pozostałości antybiotyków z wosku. Jakie są konsekwencje stosowania antybiotyków.
-
Burzyńska MartaCzym się charakteryzuje prawidłowo pozyskany miód malinowy i jakie wymogi prawne musi spełnić, aby mógł zostać uznany za odmianowy. Jaki jest skład miodu malinowego.
-
Kania ArturJak starzeją się pszczoły? Po czym można poznać wiek nieoznakowanej matki? Czy faktycznie wiek pszczół jest związany z funkcjami pełnionymi przez nie w rodzinie?
-
Martyna Walerowicz
-
Martyna Walerowicz
-
Martyna Walerowicz
-
-
Wydawnictwo Pasieka
-
-
-
-
Wielińska Agnieszka
-
-
Martyna Walerowicz
-
Paleolog Jerzy
-
Burzyńska Marta
-
Waś Ewa
-
Kania Artur
-
Maciej Sylwester Bryś
-
Trzybiński Sławomir
-
Jaroński Jakub
-
Hołderna-Kędzia Elżbieta
-
-
Martyna Walerowicz
-
Martyna Walerowicz
-
-
Wydawnictwo Pasieka
-
Burzyńska Marta
-
Waś Ewa
-
Wydawnictwo Pasieka
-
Mazur Ewa
-
Trzybiński Sławomir
-
Jaroński Jakub
-
-
-
Martyna Walerowicz
-
Martyna Walerowicz
-
Martyna Walerowicz
-
-
-
-
Martyna Walerowicz
-
Martyna Walerowicz
-
Martyna Walerowicz
-
Martyna Walerowicz
-
Rafał Szyrszeń
-
-
Mazur Ewa
-
Martyna Walerowicz
-
-
Martyna Walerowicz
-
-
Martyna Walerowicz
-
Wydawnictwo Pasieka
-
Burzyńska Marta
-
Maciej Sylwester Bryś
-
Stasiowska Dagmara
-
Rafał Szyrszeń
-
Martyna Walerowicz
-
Martyna Walerowicz
-
Martyna Walerowicz
-
Martyna Walerowicz
-
Martyna Walerowicz
-
Gajda Anna
-
Burzyńska Marta
-
Kluska Karol
-
Maciej Sylwester Bryś
-
-
Martyna Walerowicz
-
Martyna Walerowicz
-
-
-
-
-
Szeliga Przemysław
-
Szeliga Przemysław
-
Bieńkowska Małgorzata
-
Bieńkowska Małgorzata
-
Gajda Anna
-
Martyna Walerowicz
-
Martyna Walerowicz
-
Jaroński Jakub
-
Jaroński Jakub
-
Martyna Walerowicz
-
Martyna Walerowicz
-
Martyna Walerowicz
-
-
Burzyńska Marta
-
Trojan Agata
-
Kluska Karol
-
Rafał Szyrszeń
-
-
Martyna Walerowicz
-
Martyna Walerowicz
-
Martyna Walerowicz
-
-
Martyna Walerowicz
-
-
Gajda Anna
-
Surowiec Marian
-
-
Wielińska Agnieszka
-
Wielińska Agnieszka
-
Martyna Walerowicz
-
-
Martyna Walerowicz
-
-
Nicewicz Agata
-
-
Maciej Sylwester Bryś
-
Mazur Ewa
-
Wielińska Agnieszka
-
Martyna Walerowicz
-
Martyna Walerowicz
-
Martyna Walerowicz
-
Martyna Walerowicz
-
Martyna Walerowicz
-
-
Martyna Walerowicz
-
Gajda Anna
-
Burzyńska Marta
-
Maciej Sylwester Bryś
-
Zawilak Michał
-
Woyke Jerzy
-
Wielińska Agnieszka
-
Martyna Walerowicz
-
Martyna Walerowicz
-
-
-
Martyna Walerowicz
-
Martyna Walerowicz
-
Martyna Walerowicz
-
Wielińska Agnieszka
-
-
Gajda Anna
-
Nicewicz Agata
-
-
Burzyńska Marta
-
Woyke Jerzy
-
-
-
Martyna Walerowicz
-
Martyna Walerowicz
-
Martyna Walerowicz
-
Martyna Walerowicz
-
Martyna Walerowicz
-
Martyna Walerowicz
-
-
Martyna Walerowicz
-
Martyna Walerowicz
-
Martyna Walerowicz
-
-
Martyna Walerowicz
-
Martyna Walerowicz
-
Martyna Walerowicz
-
Martyna Walerowicz
-
Martyna Walerowicz
-
Martyna Walerowicz
-
Martyna Walerowicz
-
Martyna Walerowicz
-
Martyna Walerowicz
-
Martyna Walerowicz
-
Martyna Walerowicz
-
Martyna Walerowicz
-
Martyna Walerowicz
-
Martyna Walerowicz
-
-
Wielińska Agnieszka
-
-
Martyna Walerowicz
-
Gajda Anna
-
Burzyńska Marta
-
-
Łopuch Sylwia
-
-
Burzyńska Marta
-
Woyke Jerzy
-
Martyna Walerowicz
-
-
Martyna Walerowicz
-
-
Martyna Walerowicz
-
Bieńkowska Małgorzata
-
Martyna Walerowicz
-
Sierpińska Anna
-
Ptaszyńska Aneta
-
Burzyńska Marta
-
Leleń Monika
-
Piątek Michał
-
Martyna Walerowicz
-
Wielińska Agnieszka
-
Martyna Walerowicz
-
Martyna Walerowicz
-
Martyna Walerowicz
-
Martyna Walerowicz
-
-
-
Sierpińska Anna
-
Bieńkowska Małgorzata
-
Łopuch Sylwia
-
Burzyńska Marta
-
Martyna Walerowicz
-
Martyna Walerowicz
-
Martyna Walerowicz
-
-
Martyna Walerowicz
-
Martyna Walerowicz
-
-
Martyna Walerowicz
-
Martyna Walerowicz
-
Martyna Walerowicz
-
Bieńkowska Małgorzata
-
Paleolog Jerzy
-
Gajda Anna
-
Martyna Walerowicz
-
Witkowska Paulina
-
-
Martyna Walerowicz
-
Martyna Walerowicz
-
-
Martyna Walerowicz
-
Martyna Walerowicz
-
Martyna Walerowicz
-
-
Kobiałka Teresa
-
Kobiałka Teresa
-
Paleolog Jerzy
-
Gajda Anna
-
-
Witkowska Paulina
-
Martyna Walerowicz
-
-
-
Martyna Walerowicz
-
-
Gajda AnnaPszczelarskie kompendium wiedzy o warrozie, cz. 4. Przeciwwarrozowe produkty lecznicze weterynaryjne
-
Bieńkowska Małgorzata
-
Wydawnictwo Pasieka
-
-
-
Wydawnictwo Pasieka
-
Martyna Walerowicz
-
Martyna Walerowicz
-
Martyna Walerowicz
-
-
Bieńkowska MałgorzataCzym się kierować przy wyborze podgatunku (rasy) pszczół, który chcemy wprowadzić do naszej pasieki?
-
Gajda Anna
-
Wydawnictwo Pasieka
-
Martyna Walerowicz
-
Martyna Walerowicz
-
Martyna Walerowicz
-
-
-
Gajda Anna
-
-
Martyna Walerowicz
-
-
-
-
Martyna Walerowicz
-
Martyna Walerowicz
-
Martyna Walerowicz
-
Gajda Anna
Najpopularniejsze tagi
- W MOJEJ PASIECE
- NAUKA W PASIECE
- Wiadomości z Polski
- Wiadomości ze świata
- PRZYRODA WOKÓŁ PASIEKI
- WYDARZENIA
- Rośliny miododajne
- CHOROBY I SZKODNIKI PSZCZÓŁ
- Miód
- GOSPODARKA PASIECZNA
- Akcje / inicjatywy społeczne
- Artykuł udostępniony w całości
- Biologia pszczoły
- Z PASIEKĄ W ŚWIAT
- Rośliny pożytkowe
- Warroza
- Matki pszczele
- Odkrycia naukowe
- Ogrody miododajne
- Produkcja miodu

.jpg)



































































.jpg)






























































